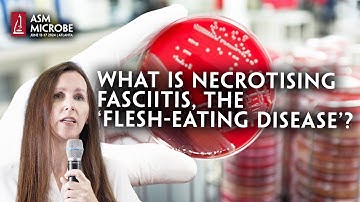
What Is Necrotising Fasciitis, The ‘Flesh-Eating Disease’?

⬇ DOWNLOAD NOW
Kalau muncul iklan pop-up, tutup lalu klik tombol kembali
Download lagu What Is Necrotizing Fasciitis? secara gratis hanya untuk keperluan promosi. Dukung artis favorit kamu dengan membeli musik original di iTunes atau platform resmi lainnya.
 Flesh Eating Disease - Necrotizing Fasciitis- Infectious Disease Doctor Explains
Flesh Eating Disease - Necrotizing Fasciitis- Infectious Disease Doctor Explains
 Flesh Eating Bacteria (Necrotizing fasciitis)
Flesh Eating Bacteria (Necrotizing fasciitis)
 Necrotizing Fasciitis .Everything You Need To Know - Dr. Nabil Ebraheim
Necrotizing Fasciitis .Everything You Need To Know - Dr. Nabil Ebraheim
 Necrotizing Fasciitis
Necrotizing Fasciitis
 Necrotizing Fasciitis: Early Diagnosis and Treatment of Flesh-Eating Disease
Necrotizing Fasciitis: Early Diagnosis and Treatment of Flesh-Eating Disease
 Necrotizing Fasciitis - Everything You Need To Know - Dr. Nabil Ebraheim
Necrotizing Fasciitis - Everything You Need To Know - Dr. Nabil Ebraheim
What Is Necrotising Fasciitis, The ‘Flesh-Eating Disease’?
What Is Necrotising Fasciitis, The ‘Flesh-Eating Disease’?
 Symptoms and effects of Necrotizing fasciitis
Symptoms and effects of Necrotizing fasciitis